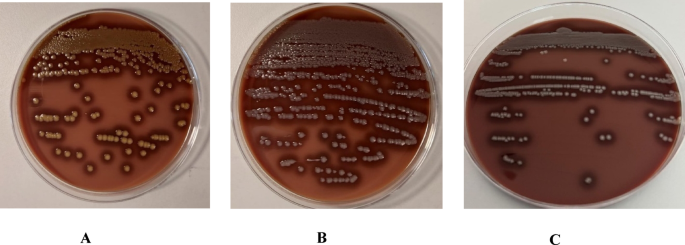
Fig. 2

Abstract
Chryseobacterium spp. are Gram-negative, opportunistic pathogens antibiotic-resistant commonly found in the environment. The aim of this study was to investigate potential sources of Chryseobacterium infections in healthcare settings by comparing clinical and environmental isolates using phenotypic and genotypic analyses. Between June and July 2023, six cases of infection with Chryseobacterium spp. were identified in a hospital in Apulia, southern Italy. Environmental sampling (air, surfaces and water) was performed in parallel with routine clinical investigations. Isolates were subjected to antibiotic susceptibility testing and genotypic analysis using Sanger and Next-Generation Sequencing. Five cases of Chryseobacterium spp. infection were recorded in the Gastroenterology Department (Pavilion A) and one in the Vertebral Surgery Department (Pavilion B). C. indologenes was identified in blood and tracheal aspirate samples using MALDI-TOF MS. Environmental analysis carried out in the pavilions A and B isolated C. indologenes from sink tap in Pavilion B. Subsequently, genome sequencing revealed that Chryseobacterium strains misidentified as C. indologenes were more closely related to C. arthrosphaerae. Genetic analysis confirmed the cluster hypothesis involving four patients from the pavilion A, while no genetic link was found between the environmental and clinical strains. Innovative molecular methods in clinical and environmental investigations have allowed more accurate identification of the etiologic agent and possibly tracing the source of infection in the nosocomial setting. Control measures, such as patient isolation and room disinfection, have prevented the spread of infection.
Similar content being viewed by others
Introduction
Until a few years ago, the genus Chryseobacterium belonged to the family Flavobacteriaceae on the basis of phylogenetic and phenotypic characteristics1,2. However, according to a recent taxonomic classification, the genus Chryseobacterium spp belongs to the new family Weeksellaceae and includes 184 species and two subspecies3,4. These bacteria are widespread in nature and have been isolated from a variety of environmental sources, including freshwater, soil, and plants. Additionally, they have been detected in food products such as raw milk, poultry, and fish, indicating their ecological versatility and ability to survive in diverse habitats2,5,6. Chryseobacterium spp. are Gram-negative, rod-shaped, non-motile, non-spore-forming bacilli that typically produce yellow-pigmented colonies. They are oxidase- and catalase-positive, and their phenotypic characteristics facilitate preliminary identification. Initial identification generally relies on culture-based methods, followed by phenotypic characterization through biochemical assays or automated systems (e.g. Phoenix and Vitek). More advanced techniques, such as Matrix-Assisted Laser Desorption/Ionization Time-of-Flight Mass Spectrometry (MALDI-TOF MS), offer faster and more accurate identification, while species-level resolution is commonly achieved using molecular methods, including genetic sequencing2,7,8.
Clinically, Chryseobacterium spp. are part of the group of less common non-fermenting Gram-negative bacilli (NFGNB), alongside species such as Stenotrophomonas maltophilia, Burkholderia cepacia complex, Alcaligenes xylosoxidans, and Elizabethkingia spp. These microorganisms are increasingly recognized as opportunistic pathogens responsible for healthcare-associated infections, particularly in immunocompromised patients9,10. Emergent data suggest that Chryseobacterium spp. may represent an increasing threat to patient health, particularly in the hospital setting. They are capable of colonizing immunocompromised patients through contaminated medical devices containing fluids, such as respirators, intubation tubes, humidifiers, catheters, and syringes11,12.
Overall, infections caused by Chryseobacterium spp. pose a significant public health concern, with a reported lethality rate of 54.8%, largely due to their resistance to multiple antibiotic classes (cephalosporins, carbapenems, aminoglycosides, and polymyxins)13. Conversely, they may remain susceptible to fluoroquinolones, macrolides, and rifampicin. Notably, there are currently no standardized guidelines for antimicrobial susceptibility testing of the Chryseobacterium genus14.
Among different species of the genus Chryseobacterium, C. indologenes and C. gleum are the most frequently associated with human infections, particularly catheter-related bloodstream infections and ventilator-associated pneumonia, while other species are only rarely implicated in human pathology2,4,15,16,17.
C. indologenes has increasingly been reported in recent years as an emerging nosocomial pathogen, particularly associated with cases of bacteremia and lower respiratory tract infections in immunocompromised patients and neonates undergoing mechanical ventilation18,19,20,21,22.
Among the species that rarely cause disease in humans is C. arthrosphaerae, first identified in 2010 after being isolated from the faeces of Arthrosphaera magna (pill millipede)5. Recently, it was isolated from the blood of a patient with liver cirrhosis resistant to all antibiotics tested and from the cerebrospinal fluid of a patient with meningitis2,14.
Between June and July 2023, six cases of infection or colonization by Chryseobacterium spp. occurred in patients hospitalized in two separate pavilions of a large hospital located in the Apulia region (Southern Italy). Because nosocomial infection was suspected, environmental investigations on air, surfaces, and water sample were conducted beyond the routine investigations on clinical samples.
The aim of this study was to identify the potential source and transmission pathway of infection by comparing clinical and environmental isolates of Chryseobacterium spp. through both phenotypic and genotypic characterization.
Materials and methods
Study design
The case series under investigation occurred between June and July 2023 in the largest hospital in Southern Italy, characterized by a pavilion structure comprising 1,550 beds in 33 separate buildings. The cases specifically involved two distinct Pavilions (A and B), located approximately 300 m apart, each supplied by separate water sub-centers.
Pavilion A consisted of five floors, including the ground floor and basement. The first floor accommodated the Gastroenterology Department, which consisted of five rooms, each equipped with two beds and one bathroom with a sink and a shower.
Pavilion B comprised three floors, including the ground floor and basement. The second floor accommodated the Vertebral Surgery Department, which consisted of five rooms, each with one/four beds. These rooms do not have dedicated bathrooms, but a single shared bathroom available in the corridor for patient use.
In accordance with the clinical and environmental monitoring protocols agreed with the health management of the hospital, the Microbiology and Virology Laboratory analyzed clinical specimens, while the Environmental and Food Hygiene Laboratory examined environmental matrices (air, water and surfaces). Since 2020, the hospital organized “Control Room Unit” focused on infection prevention and control. In particular, it managed the surveillance of healthcare-associated infections (HAI) and epidemiological investigations. Following episodes of suspect HAI, the Control Room Unit collaborated with the Environmental and Food Hygiene Laboratory to perform environmental investigations with the aim of identifying potential sources of infection.
When the possible outbreak of Chryseobacterium was suspected in the Gastroenterology Department, the Control Room Unit designed and implemented a specific case-control study. Cases were defined as patients with a positive blood culture for Chryseobacterium spp. detected during hospitalization. Controls were defined as patients hospitalized during the same period as the cases, without laboratory evidence of infection by Chryseobacterium spp., and present at the same time of at least one of the cases.
Data were collected from medical records for both cases and controls, including the following variables:
-
Age.
-
Sex.
-
Condition of immunodeficiency.
-
Invasive procedure during hospitalization.
-
Use of urinary catheter during hospitalization.
-
Use of intravascular catheter during hospitalization.
Data were entered into a database created by Ms Excel and analyzed by Stata MP18; Odds Ratios for each determinant, with 95% Confidence Intervals, were calculated, and significance was set at p < 0.05.
All protocols and experimental methods were approved by the Ethics Committee “Gabriella Serio” of Cancer Institute “Giovanni Paolo II” at IRCCS of Bari in Italy. The requirement for informed consent from the study subjects was waived by the Ethics Committee of IRCCS in Bari since the study sample was collected during routine clinical practices, and all personal data were anonymized prior the study. All methods were carried out in accordance with relevant guidelines and regulations of University of Bari in Italy.
In vitro clinical investigation
For each patient, two blood culture flasks (for aerobic and anaerobic microorganisms) were filled and incubated using the BacT/ALERT® 3D automated microbial detection system (bioMérieux, Marcy-l′Étoile, France). The system detects any growth (bacteria and fungi) in the blood culture bottle. After the bottles tested positive, Gram staining was performed to assess the morphology and coloring of the microorganisms.
To isolate bacteria, an aliquot of blood was sterilely withdrawn from the flagged positive flask and inoculated onto various culture media, including Chocolate Agar with PolyViteX™ (PVX), Colistin-Nalidixic Acid Agar (CNA), and MacConkey Agar (McK) (bioMérieux, Marcy-l′Étoile, France). These were incubated at 36 ± 1 °C for 24–48 h, with PVX plates kept in a 5% CO₂ atmosphere.
To isolate fungi, Sabouraud Dextrose Agar medium with 0.5% chloramphenicol (bioMérieux, Marcy-l′Étoile, France), was used and incubated at 36 ± 1 °C for five days.
A tracheal aspirate sample was also processed using the same culture media and incubation conditions. The microorganisms grown on the culture plates were identified using MALDI-TOF MS (bioMérieux, Marcy-l′Étoile, France).
Routine antibacterial susceptibility to amikacin, cefepime, cefotaxime, ceftazidime, ceftazidime/avibactam, ceftalozane/tazobactam, ciprofloxacin, gentamicin, imipenem, meropenem, piperacillina/tazobactam, tobramycin was performed using the VITEK®2 AST-N397 card (bioMérieux, Marcy-l′Étoile, France).
Minimum inhibitory concentrations (MICs) were interpreted according to the European Committee on Antimicrobial Susceptibility Testing (EUCAST) clinical breakpoints, version 13.0, 2023 (http://www.eucast.org/).
Environmental investigations
In order to identify the source of the infection, environmental analyses were promptly conducted after the cases were reported to detect the presence of Chryseobacterium spp. Samples of water, air and surface were collected from the rooms of the patients who tested positive for Chryseobacterium spp., as well as from common areas (staff changing rooms, taps water used for patient hygiene), both before and after water supply and environmental sanitation procedures.
One liter of cold water was collected in sterile bottles from the taps of the sinks and showers taps in the hospital rooms occupied by Chryseobacterium-positive patients, as well as in adjacent rooms. The samples were then transported to the laboratory at a controlled temperature (+ 4 °C). For each sample, 500 ml of water was filtered through a cellulose ester membrane (47 mm diameter, 0.45 μm pore size; Millipore, Milan, Italy) and each membrane was then placed on PVX agar plates (bioMérieux, Marcy-l′Étoile, France) and incubated at 36 ± 1 °C for 48 h.
To detect microorganisms on flat, large surfaces (e.g. regular surfaces such as bedside tables and desks), a defined 10 × 10 cm area was sampled using a sterile delimber. For irregular, small, or curved surfaces (e.g. infusion pumps, bed rail), the available area was swabbed. Swabs were placed in 4 °C refrigerated containers for immediate transport to the laboratory. Upon arrival, the samples were shaken for 20 s at room temperature. A 500 µL aliquot of the transport medium was inoculated onto PVX agar plates (both, bioMérieux, Marcy-l′Étoile, France) and incubated at 36 ± 1 °C for 48 h.
In addition, active air sampling on solid substrate was performed using the Surface Air System (SAS Super ISO 180; PBI International, Milan, Italy). For each sampling, 1000 L of air were drawn from the SAS, which was placed approximately 1 m above floor level. PVX 90 mm plates were used for microbial recovery and incubated at 36 ± 1 °C in a 5% CO2 atmosphere for 48 h.
Suspect colonies of Chryseobacterium grown on PVX from water, surfaces and air appearing smooth, circular, yellow-pigmented or white 1–2 mm in diameter were identified by MALDI-TOF MS (bioMérieux, Marcy-l′Étoile, France). The results were expressed as detected or not detected.
DNA extraction, Sanger sequencing, WGS, and sequence analysis
All isolates (clinicals and environmental) identified as Chryseobacterium spp. by MALDI TOF were received at the Istituto Zooprofilattico Sperimentale of Apulia and Basilicata (Putignano, Bari, Italy) and subjected to diagnostic genotyping investigations in order to assess their possible genetic relationship and identify the potential source of environmental contamination.
Genomic DNA was extracted from isolated colonies using the DNeasy Blood and Tissue Kit (Qiagen, Hilden, Germany), according to the manufacturer’s protocol. In order to assign a rapid taxonomic classification, PCR and Sanger sequencing of the partial 16 S rRNA gene, using 16 S rRNA universal primers 517 F and 1541R23, was first performed. The obtained amplicons were purified using ExoI/FAST AP enzyme systems (Thermo Fisher Scientific, Waltham, MA, USA). The purified PCR products were sequenced using BigDye 3.1 Ready (Applied Biosystems, Thermo Fisher Scientific, Waltham, MA, USA) and the 3130 Genetic Analyzer automated sequencer (Applied Biosystems, Thermo Fisher Scientific, Waltham, MA, USA) for electrophoresis. The sequences were imported and assembled using BioEdit software24 v.7.0.5, and the assembled sequences were used as BLAST-nucleotide input in GenBank (https://blast.ncbi.nlm.nih.gov/Blast)25.
Once the outcome of Sanger sequencing was obtained, Whole-Genome Sequencing (WGS) was required to detect any genetic correlations among the isolated bacterial strains. Starting from the previously purified genomic DNA, an indexed genomic library for each isolate was prepared using the Illumina DNA Prep Sample Preparation Kit (Illumina, San Diego, CA), as described26. A 2 × 250 paired-end sequencing run was performed on the Illumina MiSeq platform.
Primary bioinformatics analyses were performed following a customized Galaxy v23.0.2 workflow at Galaxy Europe platform (https://usegalaxy.eu/), that includes read quality control with fastp27, de novo sequence assembly with SPAdes28, gene prediction with Prokka29, assembly quality and contamination check with QUAST and Checkm30,31.
Species attribution was performed by means of ribosomal Multi-locus sequence typing (rMLST, https://pubmlst.org/species-id)32 and JSpecies (pairwise Average Nucleotide Identities ANI, calculated by BLAST + and MUMmer, https://jspecies.ribohost.com/jspeciesws/#home)33. The 95% ANI cutoff was considered as the similarity threshold for attributing genome assemblies to species C. arthrosphaerae (NCBI reference genome: strain_LMY, NZ_CP073074.1). Furthermore, pairwise genetic comparison among the sequenced samples was carried out by pairwise ANI calculation (FastANI tool v1.34)34. Given the scarcity of complete public C. arthrosphaerae genome sequences, a reliable Core Genome Multi-Locus Sequence Typing scheme cannot be generated. Thus, a reference-based genetic approach was considered: specifically, whole genome SNP analysis was conducted, by using Galaxy-Snippy variant caller v 4.6.035 on the investigated datasets and the above mentioned C. arthrosphaerae reference genome. The global SNP matrix table was polished by removing variant clusters (i.e., variants located ± 10 bp each other) and highly polymorphic sites (> 2 identified alleles per site). SNP differences among samples were evidenced through GrapeTree v1.5 software (implemented in March 2025)36. Furthermore, FASTA-formatted SNP table was given as input to IQ-Tree webserver (http://iqtree.cibiv.univie.ac.at/)37, that efficiently performs base composition check, nucleotide substitution model selection (model selected: TVM + F + ASC, as defined in: https://iqtree.github.io/doc/Substitution-Models), ultra-fast bootstrapping (n = 1000 bootstrap) and consensus Maximum-Likelihood phylogenetic tree construction.
Results
Outbreak description
On 3 July 2023, five cases of Chryseobacterium spp. infection were reported in patients admitted to the Gastroenterology Department (Pavilion A).
The first patient (M.L.E. Gast_1), a 65-year-old woman, was admitted on 31 May 2023 for acute liver failure after transfer from Infectious Diseases Ward of another hospital of Apulia region, Italy, and the first symptoms (fever) related to an infection with Chryseobacterium spp. appeared on 7 June 2023, with a positive blood culture on 9 June 2023. This was followed by another blood culture on 12 June that was positive for the same microorganism.
After treatment with cefepime 2 g × 3/day and vancomycin 1 g x ×2/day, the patient had two negative blood cultures on 19 and 20 June 2023, respectively. The patient underwent gastroscopy on 16 June 2023 and colonoscopy on 13 June 2023. Due to the worsening clinical condition and positive blood culture (3 July 2023) for the same microorganism, the patient was transferred to the Intensive Care Unit on 4 July 2023.
The second patient (B.K. Gast_2), a 59-year-old woman, was admitted on 10 June 2023 for anemia. On 14 June 2023, she underwent gastroscopy; in the same day, she presented fever, for which blood culture was carried out, positive for Chryseobacterium spp. She received Ceftriaxon 2 g × 1/die for 6 days; after treatment, symptoms disappeared, and blood culture resulted negative. On 21 June she was discharged in good health condition.
The third patient (C.M.M.C. Gast_3), a 68-year-old woman, affected by diabetes, was admitted on 19 June 2023 for multifocal hepatocarcinoma and was evaluated for inclusion on the transplant list. After dyspnea and fever she underwent a blood culture on 28 June which was positive for Chryseobacterium spp. The patient received antibiotic therapy with piperacillin/tazobactam 4,5 g × 3/die with improvement in respiratory symptoms and subsequent blood culture on 5 and 8 July 2023 with negative result. The patient underwent gastroscopy with ligation of esophageal varices on 28 June 2023.
The fourth patient (V.M. Gast_4), a 68-year-old man, was admitted on 26 June 2023. She had undergone liver transplantation and was undergoing ligation of esophageal varices. Again, following the onset of fever, a blood culture was taken on 30 June, which was positive for Chryseobacterium spp. The patient received antibiotic therapy with ceftriaxone 2 g × 1/die from 30 June and repeated blood culture on 1 and 3 July 2023 with positive result. After, the patient received antibiotic therapy with piperacillin/tazobactam 4,5 g × 3/die and subsequent blood cultures on 5 July 2023 with negative result.
Finally, the fifth patient (T.V. Gast_5), a 61-year-old man, a kidney transplant recipient from the Surgery Unit and on drug treatment with mycophenolate and cyclosporine, was admitted on 27 June 2023 with abdominal pain of unspecified diagnosis. After the onset of fever, blood culture was performed on 28 June 2023, which was positive for Chryseobacterium spp. He received ceftriaxon 2 g ×1/die for 6 days. After clinical deterioration (septic shock), the patient was transferred and admitted to the Intensive Care Unit in isolation on 30 June 2023 and blood culture negative on 1 and 2 July 2023. Then he was intubated on 5 July 2023 for worsening of the respiratory situation. Figure 1 shows the incidence curve of Chryseobacterium infection cases in the Gastroenterology Department.
Incidence curve of cases of Chryseobacterium spp. in Gastroenterology Department of Italian Southern hospital.
On 10 July 2023, a case of Chryseobacterium spp. infection was reported in a patient admitted to the Vertebral Surgery Department (Pavilion B).
The patient (A.A. Vert_1), a 85-year-old woman, was admitted on 24 June 2023 following a sub capitate fracture of the right femur. After three days the patient had a fever peak, and the culture test performed on 3 July 2023 on tracheal aspirate revealed the presence of Chryseobacterium spp. On 5 July 2023 chest x-rays showed pleural effusion, and the patient combined intravenous therapy with ceftriaxon 2 g × 1/die + linezolid 600 mg × 2/die, clarithromycin 500 mg × 2/die. On 13 July 2023, the patient had negative tracheal aspirate for Chryseobacterium and positive for Klebsiella pneumoniae. Table 1 shows information relating to six cases of infection by Chryseobacterium spp.
Case-control study
A total of ten patients hospitalized in the same Gastroenterology Department were enrolled. Five patients with Chryseobacterium infection were classified as cases, while five patients without the infection served as controls. Among the ten subjects (six males and four females), the overall average age was 63 ± 8.4 years (range 55–82). Among the five cases (two males), the overall average age was 64.0 ± 3.9 years; among the five controls (four male), it was 62.0 ± 11.9 years. No association was found between Chryseobacterium infection and the determinants investigated (Table 2).
Containment measures
To prevent the spread of microorganism, a number of preventive measures were taken: reorganization of beds to spatially isolate patients with positive blood cultures; blocking admissions until the outbreak was resolved and performing blood cultures on other in-patients sharing the room to detect new positive cases; analysis for Chryseobacterium spp. in environmental matrices (water, air, surfaces); disinfection of the environment following environmental investigations.
Clinical investigations
Microscopic examination of the blood and tracheal aspirate samples revealed the presence of Gram-negative bacilli. Culture examination revealed the growth of yellowish colonies from the blood culture (Fig. 2A) and white colonies from the tracheal aspirate (Fig. 2B) and water sample (Fig. 2C) only on PVX plates. Species identification by MALDI-TOF was 99% for C. indologenes. Antimicrobial susceptibility patterns of blood culture and tracheal aspirate isolates showed that all clinical isolates were resistant to all antibiotics tested, with the exception of the strain from patient M.L.E. Gast_1, which showed sensitivity to the antibiotics cefepime and ceftolozane/tazobactam (Table 3).
Environmental investigations
On 4 July 2023, in the Gastroenterology Department (Pavilion A), ten water samples were collected from sinks and showers in inpatients bathrooms on the first floor, along with two additional samples from staff changing room sinks on the mezzanine floor. Furthermore, two water samples were taken from the Apulian Aqueduct adduction point, specifically from the reservoir and the water supply inlet. On the same data, 10 air samples and 48 surface samples were also taken from inpatient rooms and bathrooms.
Following environmental sanitation procedures conducted on 14 July 2023, the same types of samples (water, air, and surfaces) were collected again for verification.
In the Vertebral Surgery Department (Pavilion B), on 10 July 2023, one air sample and eight surface samples were collected in the room of a patient who tested positive for Chryseobacterium spp. On 11 July 2023, six water samples were collected from showers and sinks in the patient’s room and the adjacent room. On 17 July 2023, an additional water sample was collected from a washbasin on the same floor, which was used for patient hygiene.
Moreover, on 6 July 2023, 18 samples of surface were collected in two boxes of the Intensive Care Unit II, where patients positive for Chryseobacterium spp. had been transferred.
Overall, Chryseobacterium spp. was not detected in any air or surface samples collected across all wards where infection cases had occurred. The bacterium was identified in only one water sample, taken from the tap of the washbasin used to clean patients in the Vertebral Surgery Department. After the installation of a point-of-use filter, a follow-up water sample from the same tap tested negative for Chryseobacterium spp.
Antimicrobial susceptibility pattern of the isolate from water showed that it was resistant to most antibiotics except some cephalosporins, penicillins and β-lactams (Table 3).
Images of colonies of Chryseobacterium spp. from (A) blood (yellow colour), (B) tracheal aspirate (white colour) and (C) water (white colour) grown on PVX agar plates.
In silico analyses
Overall, five colonies of Chryseobacterium spp. isolated from clinical specimens (four from blood cultures and one from a tracheal aspirate), each corresponding to one of the five patients involved in the suspected outbreak were analyzed in silico. In addition, the strain isolated from the water sample positive for the microorganism was analyzed. Unfortunately, the Chryseobacterium spp. strain isolated from the blood culture of one of the five patients (B.K. Gast_2) admitted to the Gastroenterology Department was not preserved.
All clinical and environmental isolates identified by MALDI-TOF as C. indologenes were found to belong to the species C. arthrosphaerae (Table 4), by Sanger sequencing of a portion of the 16 S rRNA gene (approximately 960 bp long), with a query cover rate of 99% and an identity rate ranging from 97.54% to 99.48%. The five strains isolated from patients admitted to Pavilions A and B and the strain isolated from water in Pavilion B were then subjected to whole genome sequencing. Details for the sequenced genomes are reported in Supplementary (Supplementary Table 1): a 5.2 Mbp long genome was generally obtained, with a 38% GC content. Genomic pairwise comparison evidenced a very strong sequence similarity among M.L.E Gast_1, C.M.M.C Gast_3, V.M. Gast_4, and T.V Gast_5 isolates (greater than 99.99% similar each other, Table 5).
A more detailed view was provided by wgSNP analysis. The four above-mentioned isolated have only < 5 SNP differences (out of 52590 variant sites), while the strains isolated from A.A. Vert_1 and the environment are very distant to the genetic cluster from Pavilion A Gastroenterology, (Fig. 3A). Maximum-likelihood tree (Fig. 3B) provides a consistent picture. ML-based phylogenesis on the 52,590 variant sites clearly supports the idea that the strains isolated from patients M.L.E. Gast_1, C.M.M.C. Gast_3, V.M. Gast_4, and T.V. Gast_5 have a very close common ancestor, while the isolate from patient A.A. Vert_1 and the isolate from water sample Vert_2 are very distant.
(A) GrapeTree for SNP differences among investigated samples (colored according to Legend); red integer numbers: differences among nodes, with samples with < 5 differences clustered together; for visualization purposes, branch with > 20,000 differences has been shortened (dashed line); (B) Maximum Likelihood Tree: red floating numbers indicate branch lengths; violet bubbles, indicate branch support (according to bootstrap analysis).
Discussion
In our study, genetic analysis of the isolates supported the hypothesis of an outbreak infection involving four patients from the Gastroenterology Department. Although the analysis was based on a very limited number of genomes, two different molecular methods (Sanger sequencing of the 16 S rRNA gene and Whole Genome Sequencing) confirmed that these isolates were C. arthrosphaerae and supported the hypothesis that the bacterial isolates from patients M.L.E. Gast_1, C.M.M.C. Gast_3, V.M. Gast_4, and TV_Gast_5 are part of the same outbreak of infection. In contrast, in the Vertebral surgical Department, the analyses did not show any genetic relationship between the clinical strain and the only environmental strain isolated from water, despite both belonging to the same C. arthrosphaerae species. Moreover, the genotypic analyses revealed that the water sample strain and the clinical strain isolated from patient A.A. Vert_1 were genetically more distant from the other strains, suggesting no direct link.
Among the Chrysobacterium species, most human infections are caused by C. indologenes38,39, while those by C. arthrosphaerae have rarely been reported. This is probably due to the misidentification of the microorganism. In accordance with previous studies, our results show that commercial phenotypic identification systems and traditional bacterial identification methods are not always reliable for the identification of Chryseobacterium species16,40. Although MALDI-TOF is a state-of-the-art system for the rapid identification of microorganisms, it is necessary for the database to be constantly updated to obtain a correct identification of the microorganisms.
In our study, MALDI-TOF identified clinical and environmental strains as C. indologenes, whereas sequencing of the 16 S rRNA gene confirmed them as C. arthrosphaerae. This challenge in species identification has been noted in previous studies2, which reported the presence of C. arthrosphaerae in a patient’s blood, although this isolate was initially identified as C. indologenes by MALDI-TOF. Liang et al.2 showed that the sequencing of the 16 S rRNA gene revealed a 100% sequence identity of strain ED882-96, wrongly identified as C. indologenes, with the CC-VM-7 type strain of C. arthrosphaerae. These findings underscore the importance of new technologies, such as NGS, for accurate microbial identification41. Moreover, NGS also plays a crucial role in tracking outbreaks and helps to determine whether patient isolates are linked to environmental strains.
A Spanish study42 shows that C. indologenes can be found in hospital environments. The authors reported the bacterium in the air and washbasins of an Intensive Care Unit following an outbreak involving 12 patients. Moreover, the same Pulsed-Field Gel Electrophoresis pattern was shared by patients and the air sample near the sink. Although the exact transmission route remained unclear, they highlighted that the washbasin could act as a reservoir for C. indologenes and other pathogenic microorganisms. In fact, after the washbasins were removed, the outbreak regressed.
In our study, unfortunately only one of the environmental samples was analyzed by WGS, so we could not definitively determine the source of the outbreak. However, we consider that the finding of C. artrosphaerae in the water of one of the two pavilions, although genotypically distinct from the clinical strain, demonstrates the possibility of nosocomial infection due to environmental contamination. Unfortunately, the number of public C. artrosphaerae complete genomes or associated raw sequences is very limited: thus, no reliable genetic comparisons (e.g., cgMLST or wgSNP analyses) can be carried out among our investigated strains and the few ones detected worldwide.
In our opinion, the finding of the microorganism in a single environmental sample out of all those examined (air, water and surfaces) was entirely fortuitum in the two pavilions where the infection occurred. Culture analysis for the detection of Chryseobacterium requires highly nutritious media such as blood agar and PVX, which may allow the overgrowth of other microorganisms present in environmental matrices42. This possibility could inhibit or mask the presence of suspect colonies that thus escape identification.
Given these challenges, it remains difficult to pinpoint the exact source of infection in both the Gastroenterology and Vertebral Surgery Departments. In particular, in the second Department, the patient was bedridden and therefore did not have access to the bathroom.
We hypothesize that healthcare workers’ hands may have played a role in transmitting the microorganism to patients, either directly or indirectly after handwashing. Water taken from the taps in the toilets and used by healthcare workers to wash bedridden patients, could have contributed to the spread of microorganisms.
To ensure the safety of patients, healthcare workers, and visitors, it is crucial to implement a comprehensive approach to hospital hygiene. This includes essential measures such as hand hygiene training for healthcare workers, proper disposal of medical waste, isolating infected patients, and conducting regular environmental monitoring to prevent cross-transmission of pathogens. In our study, after analyzing the water samples, we implemented disinfection procedures on the water network, including shock hyperchlorination and the installation of absolute filters at all tap terminals. These measures were followed by microbiological control, which confirmed the absence of pathogens.
The new European Drinking Water Directive, implemented in Italy on 18 February 2023, highlights that water is not free from microorganisms and, if improperly managed, can serve as a vehicle for infectious diseases. In hospitals, particularly where immunocompromised patients are present, it is now mandatory to adopt the Water Safety Plan by 2029. Our hospital began implementing this plan in 2020, establishing routine and operational monitoring of the water supply. In addition, in order to reduce the spread of pathogenic microorganisms in the water, the hospital’s technical management department implements a series of strategies: (i) replacement of absolute filters on faucets every 3 months, (ii) keep limescale-free or replace water faucet breakers, (iii) measurement of the concentration of residual disinfectant in the water supply, (iv) flushing of all water supply terminals (taps, showers) for 5 min for 5 days, alternating between cold and hot water43.
Despite these efforts, our study demonstrated that compulsory microbiological parameters are not always sufficient to guarantee the safety of vulnerable patients. Therefore, in epidemic situations, a more extensive risk assessment is necessary to detect other microorganisms that may contribute to nosocomial infections.
Furthermore, our findings on antimicrobial susceptibility reveal resistance to several antibiotic classes (cephalosporins, carbapenems, and aminoglycosides) in all clinical strains and a single environmental strain of Chryseobacterium spp., as indicated in existing literature, although the data remains limited. Despite this resistance, the therapeutic approach we implemented led to a positive resolution of clinical cases. This highlights the importance of continuous vigilance and tailored interventions, particularly in preventing infections in high-risk hospital environments.
Conclusion
Following the spread of C. indologenes among patients admitted to two wards at a large hospital in Apulia, sequencing results of clinical and environmental strains revealed that the isolates belonged to the species C. arthrosphaerae. This analysis confirmed the hypothesis of a cluster involving four patients from the Gastroenterology Department. Specifically, a genetic correlation was observed solely among the clinical isolates of patients in the Gastroenterology Department. No correlation was found between the environmental strain isolated from water and the clinical strains from the two involved wards.
Thanks to the timely analysis, patient isolation, and the implementation of water disinfection and environmental sanitation measures, the spread of the microorganism was halted and its transmission to other patients prevented. Therefore, it is crucial to ensure the proper implementation of routine cleaning procedures within the hospital environment to minimize the spread of microorganisms in nosocomial settings and prevent future infections.
Data availability
Sequence data that support the findings of this study have been deposited in the NCBI Genome (submission id: SUB15330113), within the NCBI BioProject PRJNA1264769.
References
Vandamme, P., Bernardet, J. F., Segers, P., Kersters, K. & Holmes, B. New perspectives in the classification of the flavobacteria: Description of Chryseobacterium gen. nov., Bergeyella gen. nov., and Empedobacter nom. Rev. Int. J. Syst. Evol. Microbiol. 44, 827–831. https://doi.org/10.1099/00207713-44-4-827 (1994).
Liang, C. Y., Yang, C. H., Lai, C. H., Huang, Y. H. & Lin, J. N. Genomic features, comparative genomic analysis, and antimicrobial susceptibility patterns of Chryseobacterium arthrosphaerae strain ED882-96 isolated in Taiwan. Genes (Basel) 10, 309. https://doi.org/10.3390/genes10040309 (2019).
García-López, M. et al. Analysis of 1000 Type-Strain genomes improves taxonomic classification of bacteroidetes. Front. Microbiol. 10, 2083. https://doi.org/10.3389/fmicb.2019.02083 (2019).
LPSN - List of Prokaryotic names with Standing in Nomenclature. Available online: https://lpsn.dsmz.de/genus/Chryseobacterium (Accessed 3 Sept 2025).
Kämpfer, P. et al. Chryseobacterium arthrosphaerae sp. nov., isolated from the faeces of the pill millipede arthrosphaera magna attems. Int. J. Syst. Evol. Microbiol. 60, 1765–1769. https://doi.org/10.1099/ijs.0.016840-0 (2010).
Jeong, J. J. et al. Chryseobacterium cucumeris sp. nov., an endophyte isolated from cucumber (Cucumis sativus L.) root, and emended description of Chryseobacterium arthrosphaerae. Int. J. Syst. Evol. Microbiol. 67, 610–616. https://doi.org/10.1099/ijsem.0.001670 (2017).
Alfouzan, W., Dhar, R., Al-hashemi, H., Al-sweih, N. & Albert, M. J. Clinical and microbiological characteristics of Chryseobacterium spp. Isolated from neonates in Kuwait. J. Med. Case Rep. 2, 1–6. https://doi.org/10.1099/jmmcr.0.001008 (2014).
Ogochukwu, E. C. et al. Detection of ESBL, AmpC, and MBL-producing Chryseobacterium indologenes isolates recovered from hospital environment in a tertiary health care facility. AMJIDM 9, 129–135 (2021). https://pubs.sciepub.com/ajidm/9/4/4/index.html
Enoch, D. A., Birkett, C. I. & Ludlam, H. A. Non-fermentative gram-negative bacteria. Int. J. Antimicrob. Agents 29, S33–41. https://doi.org/10.1016/S0924-8579(07)72176-3 (2007).
Zhou, X. et al. Antimicrobial activities of sitafloxacin and comparators against the clinical isolates of less common nonfermenting gram-negative bacteria. J. Glob Antimicrob. Resist. 30, 123–126. https://doi.org/10.1016/j.jgar.2022.06.003 (2022).
Hoque, S. N., Graham, J., Kaufmann, M. E. & Tabaqchali, S. Chryseobacterium (Flavobacterium) meningosepticum outbreak associated with colonization of water taps in a neonatal intensive care unit. J. Hosp. Infect. 47, 188–192. https://doi.org/10.1053/jhin.2000.0908 (2001).
Nulens, E., Bussels, B., Bols, A., Gordts, B. & Van Landuyt, H. W. Recurrent bacteremia by Chryseobacterium indologenes in an oncology patient with a totally implanted intravenous device. Clin. Microbiol. Infect. 7, 391–393. https://doi.org/10.1046/j.1198-743x.2001.00273.x (2001).
Zhu, L. et al. Whole-genome sequencing and analysis of Chryseobacterium arthrosphaerae from Rana nigromaculata. BMC Microbiol. 24, 80. https://doi.org/10.1186/s12866-024-03223-6 (2024).
Im, J. H. et al. Chryseobacterium arthrosphaerae ventriculitis: A case report. Med. (Baltim). 99, e21751. https://doi.org/10.1097/MD.0000000000021751 (2020).
Loch, T. P. & Faisal, M. Emerging flavobacterial infections in fish: A review. J. Adv. Res. 6, 283–300. https://doi.org/10.1016/j.jare.2014.10.009 (2015).
Lin, J. N. et al. Comparison of four automated microbiology systems with 16S rRNA gene sequencing for identification of Chryseobacterium and Elizabethkingia species. Sci. Rep. 7, 13824. https://doi.org/10.1038/s41598-017-14244-9 (2017).
Lin, J. N. et al. Comparison of the Vitek MS and Bruker matrix-assisted laser desorption ionization-time of flight mass spectrometry systems for identification of Chryseobacterium isolated from clinical specimens and report of uncommon Chryseobacterium infections in humans. J. Clin. Microbiol. 56, e00712–e00718. https://doi.org/10.1128/JCM.00712-18 (2018).
Cimmino, T. & Rolain, J. M. Whole genome sequencing for Deciphering the resistome of Chryseobacterium indologenes, an emerging multidrug-resistant bacterium isolated from a cystic fibrosis patient in Marseille, France. New. Microbes New. Infect. 12, 35–42. https://doi.org/10.1016/j.nmni.2016.03.006 (2016).
Sandino Pérez, J., Mancilla, A. M., Pérez Barragán, E. & Fernández-Ruiz, M. Chryseobacterium bacteraemia: A single-centre case series. Infect. Dis. 50, 775–778. https://doi.org/10.1080/23744235.2018.1464663 (2018).
Agarwal, S., Kakati, B. & Khanduri, S. Severe sepsis due to Chryseobacterium indologenes, a possible emergent multidrug-resistant organism in intensive care unit-acquired infections. Indian J. Crit. Care Med. 22, 817–819. https://doi.org/10.4103/ijccm.IJCCM_278_18 (2018).
Izaguirre-Anariba, D. E. & Sivapalan, V. Chryseobacterium indologenes, an emerging bacteria: A case report and review of literature. Cureus 12, e6720. https://doi.org/10.7759/cureus.6720 (2020).
Lim, W. G., Tong, T. & Chew, J. Chryseobacterium indologenes and Chryseobacterium gleum interact and multiply intracellularly in Acanthamoeba castellanii. Exp. Parasitol. 211, 107862. https://doi.org/10.1016/j.exppara.2020.107862 (2020).
Nossa, C. W. et al. Design of 16S rRNA gene primers for 454 pyrosequencing of the human foregut microbiome. World J. Gastroenterol. 16, 4135–4144. https://doi.org/10.3748/wjg.v16.i33.4135 (2010).
Hall, T. BioEdit: a user-friendly biological sequence alignment editor and analysis program for Windows 95/97/NT. in Nucleic Acids Symp Ser. 95–98 (Oxford University Press, 1999).
Altschul, S. F., Gish, W., Miller, W., Myers, E. W. & Lipman, D. J. Basic local alignment search tool. J. Mol. Biol. 215, 403–410. https://doi.org/10.1016/S0022-2836(05)80360-2 (1990).
Bianco, A. et al. Characterization of Bacillus cereus group isolates from human bacteremia by whole-genome sequencing. Front. Microbiol. 11, 599524. https://doi.org/10.3389/fmicb.2020.599524 (2021).
Chen, S., Zhou, Y., Chen, Y. & Gu, J. Fastp: an ultra-fast all-in-one FASTQ preprocessor. Bioinformatics 34, i884–i890. https://doi.org/10.1093/bioinformatics/bty560 (2018).
Bankevich, A. et al. SPAdes: A new genome assembly algorithm and its applications to single-cell sequencing. J. Comput. Biol. 19, 455–477. https://doi.org/10.1089/cmb.2012.0021 (2012).
Seemann, T. Prokka: Rapid prokaryotic genome annotation. Bioinformatics 30, 2068–2069. https://doi.org/10.1093/bioinformatics/btu153 (2014).
Gurevich, A., Saveliev, V., Vyahhi, N. & Tesler, G. QUAST: Quality assessment tool for genome assemblies. Bioinformatics 29, 1072–1075. https://doi.org/10.1093/bioinformatics/btt086 (2013).
Parks, D. H., Imelfort, M., Skennerton, C. T., Hugenholtz, P. & Tyson, G. W. CheckM: Assessing the quality of microbial genomes recovered from isolates, single cells, and metagenomes. Genome Res. 25, 1043–1055. https://doi.org/10.1101/gr.186072.114 (2015).
Jolley, K. A. et al. Ribosomal multilocus sequence typing: Universal characterization of bacteria from domain to strain. Microbiol. (Reading) 158, 1005–1015. https://doi.org/10.1099/mic.0.055459-0 (2012).
Richter, M., Rosselló-Móra, R., Oliver Glöckner, F. & Peplies, J. JSpeciesWS: A web server for prokaryotic species circumscription based on pairwise genome comparison. Bioinformatics 32, 929–931. https://doi.org/10.1093/bioinformatics/btv681 (2016).
Jain, C., Rodriguez-R, L. M., Phillippy, A. M., Konstantinidis, K. T. & Aluru, S. High throughput ANI analysis of 90K prokaryotic genomes reveals clear species boundaries. Nat. Commun. 9, 5114. https://doi.org/10.1038/s41467-018-07641-9 (2018).
Seemann, T. Snippy: Fast bacterial variant calling from Next-Generation Sequencing (NGS) reads. (2015). https://github.com/tseemann/snippy
Zhou, Z. et al. GrapeTree: visualization of core genomic relationships among 100,000 bacterial pathogens. Genome Res. 28, 1395–1404. https://doi.org/10.1101/gr.232397.117 (2018).
Trifinopoulos, J., Nguyen, L. T., von Haeseler, A. & Minh, B. Q. W-IQ-TREE: A fast online phylogenetic tool for maximum likelihood analysis. Nucleic Acids Res. 44, W232–W235. https://doi.org/10.1093/nar/gkw256 (2016).
Chen, F. L. et al. Clinical and epidemiological features of Chryseobacterium indologenes infections: analysis of 215 cases. J. Microbiol. Immunol. Infect. 46, 425–432. https://doi.org/10.1016/j.jmii.2012.08.007 (2013).
Lin, Y. T. et al. Clinical and Microbiological characteristics of Chryseobacterium indologenes bacteremia. J. Microbiol. Immunol. Infect. 43, 498–505. https://doi.org/10.1016/S1684-1182(10)60077-1 (2010).
de Carvalho Filho, É. B., Marson, F. A. L. & Levy, C. E. Challenges in the identification of Chryseobacterium indologenes and Elizabethkingia meningoseptica in cases of nosocomial infections and patients with cystic fibrosis. New. Microbes New. Infect. 20, 27–33. https://doi.org/10.1016/j.nmni.2017.09.002 (2017).
De Giglio, O. et al. Legionella anisa or Legionella bozemanii? Traditional and molecular techniques as support in the environmental surveillance of a hospital water network. Environ. Monit. Assess. 195, 496. https://doi.org/10.1007/s10661-023-11078-z (2023).
Cantero, M. et al. A cluster of Chryseobacterium indologenes cases related to drainage water in intensive care units. Infect. Control Hosp. Epidemiol. 39, 997–999. https://doi.org/10.1017/ice.2018.126 (2018).
Linee Guida per la Valutazione e la Gestione. Del Rischio per La Sicurezza dell’acqua Nei sistemi Di distribuzione interni Degli edifici prioritari e Non prioritari e in Talune navi Ai sensi Della Direttiva (UE) 2020/2184; rapporti ISTISAN 22/32 (Istituto Superiore di Sanità, Roma, Italy, 2022).
Funding
This work was not directly supported by any funding agencies.
Author information
Authors and Affiliations
Contributions
Conceptualized: Triggiano, F; Caggiano, G; De Giglio, O; Tafuri, S; Montagna, MT. Methodology: Triggiano, F; Caggiano, G; De Giglio, O; Tafuri, S. Formal analysis and investigation: Capozzi, L; Castellana, S; Diella, G; Furio, A; Cantalice, MA; Manicone, AL; Savino, AF; Mosca, A; De Carlo, C; Sparapano, E; Dalfino, L; Saracino, A; Di Gennaro, F; Principi MB; Parisi, A; Montagna, MT. Data curation: Capozzi, L; Castellana, S; Furio, A; Parisi, A; Tafuri, S. Writing Original draft preparation: Triggiano, F; Caggiano, G; De Giglio, O; Tafuri, S; Montagna, MT. All authors read and reviewed the manuscript.
Corresponding author
Ethics declarations
Competing interests
The authors declare no competing interests.
Ethical approval
This study was approved (Code number: 1345/CE-14/09/2023) by Ethics Committee “Gabriella Serio”- Istituto Tumori “Giovanni Paolo II” IRCCS, Bari, Italy.
Additional information
Publisher’s note
Springer Nature remains neutral with regard to jurisdictional claims in published maps and institutional affiliations.
Supplementary Information
Below is the link to the electronic supplementary material.
Rights and permissions
Open Access This article is licensed under a Creative Commons Attribution-NonCommercial-NoDerivatives 4.0 International License, which permits any non-commercial use, sharing, distribution and reproduction in any medium or format, as long as you give appropriate credit to the original author(s) and the source, provide a link to the Creative Commons licence, and indicate if you modified the licensed material. You do not have permission under this licence to share adapted material derived from this article or parts of it. The images or other third party material in this article are included in the article’s Creative Commons licence, unless indicated otherwise in a credit line to the material. If material is not included in the article’s Creative Commons licence and your intended use is not permitted by statutory regulation or exceeds the permitted use, you will need to obtain permission directly from the copyright holder. To view a copy of this licence, visit http://creativecommons.org/licenses/by-nc-nd/4.0/.
About this article
Cite this article
Triggiano, F., Caggiano, G., Capozzi, L. et al. Clinical and environmental investigation of six cases of Chryseobacterium arthrosphaerae infections in a Southern Italian hospital. Sci Rep 15, 39814 (2025). https://doi.org/10.1038/s41598-025-24632-1
Received:
Accepted:
Published:
Version of record:
DOI: https://doi.org/10.1038/s41598-025-24632-1